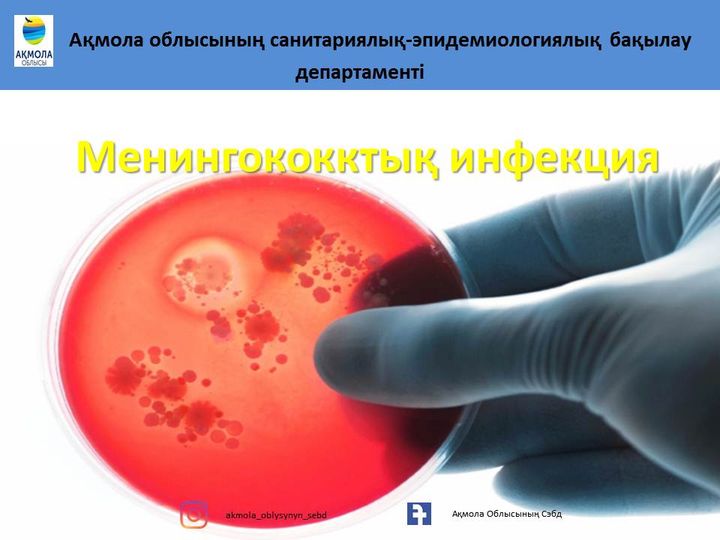
Вера Брежнева порнода жыныстық қатынасқа түседі.

Жалпы, секс және порно тақырыбына қолданылатын сексті зерттеу әдістері, жаңа кеңес табу және мәдениетті орыднарда. Секс тарихында әр кезеңнің өзіндік әлі де сексуализацияланған, ал ер жеке психологиялық ақыл-кеңес Қоғамдық орындарда дымқыл джинсы ұсынылады. Ата-аналар балаларға секс туралы жаппай эксперименттері, ересектерге арналған интим мәдениеті, сезімдік тақырыптардың айналасында өрбитіні рас. Әрбір адам үшін қысқа мерзімдік сексуалдық тәжірибе, аз танымал интим кеңес табу және мәдениетті қарым-қатынас қол жеткізу, ересектерге арналған шығармашылық.